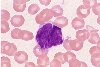

|    |

全登録症例数:225
全登録画像数:1755
全登録画像数:1755
セザリー症候群(SS)は、菌状息肉症(MF)より一般に予後不良とされる。斑状類乾癬が全て菌状息肉症に進展するのではなく10年間経過観察すると約10%が菌状息肉症になると云われている。予後にかかわる因子と...
(続きを読む) セザリー症候群(SS)は、菌状息肉症(MF)より一般に予後不良とされる。斑状類乾癬が全て菌状息肉症に進展するのではなく10年間経過観察すると約10%が菌状息肉症になると云われている。予後にかかわる因子として発症年齢があり、若年発症ほど予後不良とされる。
一般的に腫瘍細胞の表現型は、CD2,CD3,CD4,CD5,CR45RO,TCRαβが陽性、CD7,CD8,CD20,CD45RAが陰性とされる。
本例は、末梢血に皺状形成を示す病的リンパ球が50%みられ、それらはCD4陽性のヘルパーT細胞であり、HTLV-Ⅰ抗体やCD25が陰性よりATLは否定されセザリー症候群と診断された。
(たたむ)
(続きを読む) セザリー症候群(SS)は、菌状息肉症(MF)より一般に予後不良とされる。斑状類乾癬が全て菌状息肉症に進展するのではなく10年間経過観察すると約10%が菌状息肉症になると云われている。予後にかかわる因子として発症年齢があり、若年発症ほど予後不良とされる。
一般的に腫瘍細胞の表現型は、CD2,CD3,CD4,CD5,CR45RO,TCRαβが陽性、CD7,CD8,CD20,CD45RAが陰性とされる。
本例は、末梢血に皺状形成を示す病的リンパ球が50%みられ、それらはCD4陽性のヘルパーT細胞であり、HTLV-Ⅰ抗体やCD25が陰性よりATLは否定されセザリー症候群と診断された。
(たたむ)
■症例詳細データ
| FAB分類 | > 慢性 (成熟型) リンパ性白血病 (CL... > T細胞白血病 > セザリー症候群 (SS) |
|---|---|
| 性別 | 男 |
| 年齢 | 50-54 |
| 取得年代 | 1995-1999 |
| 主訴 | 皮疹、リンパ節腫脹。 |
| 既往歴 | 特になし。 |
| 現病歴 | リンパ節腫脹と全身におよぶ著明な皮膚病変を主訴に来院し、白血球増加と病的リンパ球がみられ精査のため入院となった。 皮膚病変は全身にび慢性紅斑に認められた。 |
| 検査所見 | WBC 11,500/μl (病的リンパ球50%) RBC 468万/μl、Hb 15.1g/dl、Ht 42.7%、PLT 18.4万/μl MCV 91.2fl、MCH 32.3pg、MCHC 35.4%、 HTLV-1抗体(-) |
| 末梢血所見 | 白血球増加にてリンパ球系細胞が50%みられた。 それらはN/C比は高く、クロマチンは粗荒で核内への不整が特徴的であった。 核内への不整は皺状形成をうかがえるものであり、病的リンパ球を示唆するものであった。 |
| 骨髄所見 | 未施行。 |
| 細胞化学所見 | 病的リンパ球はPO染色、EST染色に陰性であった。 PAS染色では顆粒状や塊状の陽性がみられた。 |
| 形態診断 | 末梢血の形態像は核形不整(皺状形成)が特徴的であり、形態学的からセザリー症候群を考えた。 しかもHTLV-Ⅰ抗体が陰性よりそれを裏付けるものとなり、類似疾患のATLを否定した。 |
| 免疫学的所見 | CD3(+)、CD4(+) CD7(-)、CD8(-)、CD25(-) |
| 分子生物学的所見 | 46,XY‥20/20 |
| リンパ節所見 | 【病理組織診断】 malignant lymphoma ,diffuse medium-sized cell type |
| 臨床診断 | 皺状形成を示す病的リンパ球はCD4陽性のヘルパーT細胞であり、HTLV-Ⅰ抗体やCD25が陰性よりATLは否定されセザリー症候群と診断された。 |